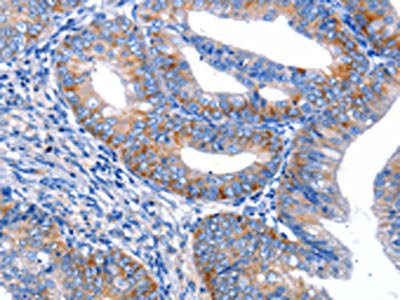

AR Antibody
-
中文名稱:AR兔多克隆抗體
-
貨號:CSB-PA056943
-
規格:¥1100
-
圖片:
-
The image on the left is immunohistochemistry of paraffin-embedded Human cervical cancer tissue using CSB-PA056943(AR Antibody) at dilution 1/20, on the right is treated with synthetic peptide. (Original magnification: ×200)
-
The image on the left is immunohistochemistry of paraffin-embedded Human thyroid cancer tissue using CSB-PA056943(AR Antibody) at dilution 1/20, on the right is treated with synthetic peptide. (Original magnification: ×200)
-
-
其他:
產品詳情
-
Uniprot No.:
-
基因名:
-
別名:AIS antibody; ANDR_HUMAN antibody; Androgen nuclear receptor variant 2 antibody; Androgen receptor (dihydrotestosterone receptor; testicular feminization; spinal and bulbar muscular atrophy; Kennedy disease) antibody; Androgen receptor antibody; androgen receptor splice variant 4b antibody; AR antibody; AR8 antibody; DHTR antibody; Dihydro testosterone receptor antibody; Dihydrotestosterone receptor (DHTR) antibody; Dihydrotestosterone receptor antibody; HUMARA antibody; HYSP1 antibody; KD antibody; Kennedy disease (KD) antibody; NR3C4 antibody; Nuclear receptor subfamily 3 group C member 4 (NR3C4) antibody; Nuclear receptor subfamily 3 group C member 4 antibody; SBMA antibody; SMAX1 antibody; Spinal and bulbar muscular atrophy (SBMA) antibody; Spinal and bulbar muscular atrophy antibody; Testicular Feminization (TFM) antibody; TFM antibody
-
宿主:Rabbit
-
反應種屬:Human
-
免疫原:Synthetic peptide of Human AR
-
免疫原種屬:Homo sapiens (Human)
-
標記方式:Non-conjugated
-
抗體亞型:IgG
-
純化方式:Antigen affinity purification
-
濃度:It differs from different batches. Please contact us to confirm it.
-
保存緩沖液:-20°C, pH7.4 PBS, 0.05% NaN3, 40% Glycerol
-
產品提供形式:Liquid
-
應用范圍:ELISA,IHC
-
推薦稀釋比:
Application Recommended Dilution ELISA 1:1000-1:5000 IHC 1:25-1:100 -
Protocols:
-
儲存條件:Upon receipt, store at -20°C or -80°C. Avoid repeated freeze.
-
貨期:Basically, we can dispatch the products out in 1-3 working days after receiving your orders. Delivery time maybe differs from different purchasing way or location, please kindly consult your local distributors for specific delivery time.
-
用途:For Research Use Only. Not for use in diagnostic or therapeutic procedures.
相關產品
靶點詳情
-
功能:Steroid hormone receptors are ligand-activated transcription factors that regulate eukaryotic gene expression and affect cellular proliferation and differentiation in target tissues. Transcription factor activity is modulated by bound coactivator and corepressor proteins like ZBTB7A that recruits NCOR1 and NCOR2 to the androgen response elements/ARE on target genes, negatively regulating androgen receptor signaling and androgen-induced cell proliferation. Transcription activation is also down-regulated by NR0B2. Activated, but not phosphorylated, by HIPK3 and ZIPK/DAPK3.; Lacks the C-terminal ligand-binding domain and may therefore constitutively activate the transcription of a specific set of genes independently of steroid hormones.; Lacks the C-terminal ligand-binding domain and may therefore constitutively activate the transcription of a specific set of genes independently of steroid hormones.
-
基因功能參考文獻:
- AR expression heterogeneity is linked to distinct castration/enzalutamide responses in castration-resistant prostate cancer. PMID: 30190514
- Androgen receptor positive triple negative breast cancer: Clinicopathologic, prognostic, and predictive features PMID: 29883487
- In prostate cancer cells, AR-V7 expression is correlated with drug resistance, as AR-V7 upregulation leads to enhanced proliferation potency of cancer cells, indicating unfavorable prognosis of patients. PMID: 30284554
- These findings imply that the deep intronic mutation creating an alternative splice acceptor site resulted in the production of a relatively small amount of wildtype androgen receptor mRNA, leading to partial androgen insensitivity syndrome. PMID: 29396419
- AR Germline Mutations and Polymorphisms were associated with Prostate Cancer. PMID: 30139231
- GTEE also downregulated the expression of AR and prostate-specific antigen (PSA) in both androgen-responsive and castration-resistant PCa cells. By blocking the SREBP-1/AR axis, GTEE suppressed cell growth and progressive behaviors, as well as activating the caspase-dependent apoptotic pathway in PCa cells PMID: 30301150
- Suppressed the expression of androgen receptor. PMID: 29981500
- An AR motif of the transactivation domain has been identified that contributes to transcriptional activity by recruiting the C-terminal domain of subunit 1 of the general transcription regulator TFIIF. PMID: 29225078
- In LNCaP prostate cancer cells, TSG101 overexpression recruits the androgen receptor (AR) to TSG101-containing cytoplasmic vesicles resulting in reduced AR protein level and AR transactivation activity downregulation. Immunofluorescence microscopy demonstrated that TSG101-decorated cytoplasmic vesicles are associated with late endosomes/lysosomes. PMID: 29859188
- Study indicates that both mRNA and protein level of AR increase during prostate cancer (PCa) progression. These levels are even higher in metastatic PCa. Further data suggest that elevation of AR may promote PCa metastasis by induction of EMT and reduction of KAT5. PMID: 30142696
- This study aimed to determine the presence and localization of oestrogen receptors (ERs), progesterone receptors (PRs), and androgen receptors (ARs) in both healthy and varicose vein wall cells and their relationship with gender. PMID: 30250632
- These findings suggest that CDK11 is involved in the regulation of AR pathway and AR can be a potential novel prognostic marker and therapeutic target for osteosarcoma treatment. PMID: 28262798
- We use CPRC prostate cancer model and demonstrate that endothelial cells secrete large amount of CCL5 and induces autophagy by suppressing AR expression in prostate cancer cell lines. Consequently, elevated autophagy accelerates focal adhesions proteins disassembly and promoted prostate cancer invasion. Inhibition of both CCL5/CCR5 signaling and autophagy significantly reduces metastasis in vivo PMID: 30200999
- Overexpression of nuclear AR-V7 protein identifies a subset of tumors with remarkably aggressive growth characteristics among clinically and histologically high-risk patients at the time of radical prostatectomy. PMID: 29198908
- Study defines AR ligand-binding domain homodimerization as an essential step in the proper functioning of this important transcription factor. Dimerization surface harbours over 40 previously unexplained androgen insensitivity syndromes and prostate cancer-associated point mutations. PMID: 28165461
- Loss of AR expression was found in the nucleus of penile cancer cells when compared to normal tissues. Cytoplasmic AR immunostaining was observed in a significant number of these cases and was related with poor prognosis and shorter overall survival. PMID: 30099587
- The AR polymorphism is associated with POR risk, patients with repeats greater than 22 show a higher risk. Our data suggest that AR genotype could play a role in natural ovarian aging. PMID: 29886316
- In all, these data suggest that Aurora A plays a pivotal role in regulation of Androgen receptor variant 7 expression and represents a new therapeutic target in castrate-resistant prostate cancer. PMID: 28205582
- The meta-analysis showed that short CAG and GGN repeats in androgen receptor gene were associated with increased risk of prostate cancer, especially in Caucasians. PMID: 28091563
- Knockdown of beta-Klotho produced the opposite effects. In conclusion, beta-Klotho inhibits EMT and plays a tumorsuppressive role in prostate cancer (PCa) , linking FGF/FGFR/beta-Klotho signaling to the regulation of PCa progression. PMID: 29749458
- The interaction of AR and SP1 contributes to regulate EPHA3 expression. PMID: 29917167
- DHX15 regulates androgen receptor (AR) activity by modulating E3 ligase Siah2-mediated AR ubiquitination independent of its ATPase activity promoting prostate cancer progression. PMID: 28991234
- The interaction of Nanog with the AR signaling axis might induce or contribute to Ovarian cancer stem cells regulation. In addition, androgen might promote stemness characteristics in ovarian cancer cells by activating the Nanog promoter PMID: 29716628
- a significant subset of endometrial cancers express androgen receptor especially a serous cancers. PMID: 29747687
- Letter: eradication of androgen receptor amplification, PSA decline, and clinical improvement with high dose testosterone therapy. PMID: 28040353
- The results in this meta-analysis indicated that AR CAG and GGN repeat polymorphisms may be an important pathogenesis of cryptorchidism. PMID: 29044734
- the inverse relation observed between bone cell activity and tumor cell AR activity in prostate cancer bone metastasis may be of importance for patient response to AR. PMID: 29670000
- Length variations of (CAG)n and (GGC)n polymorphism in the transactivation domain of AR, significantly influence hormonal profile, semen parameters, and sexual functions of asthenospermic subjects by down regulating the expression of AR mediating signaling. PMID: 29083935
- Data suggest that somatic mosaicism in AR can cause partial androgen insensitivity syndrome. [CASE REPORT] PMID: 29267169
- These results identify HoxB13 as a pivotal upstream regulator of AR-V7-driven transcriptomes that are often cell context-dependent in CRPC, suggesting that HoxB13 may serve as a therapeutic target for AR-V7-driven prostate tumors. PMID: 29844167
- TRX1 is an actionable castration-resistant prostate cancer therapeutic target through its protection against AR-induced redox stress. PMID: 29089489
- these findings reveal AR-genomic structural rearrangements as important drivers of persistent AR signalling in castration-resistant prostate cancer. PMID: 27897170
- AR+ was associated with lower breast cancer mortality in the overall study population ( estrogen receptor-negative). PMID: 28643022
- nuclear COBLL1 interacts with AR to enhance complex formation with CDK1 and facilitates AR phosphorylation for genomic binding in castration-resistant prostate cancer model cells. PMID: 29686105
- A variety of AR mutants are induced under selective pressures of AR pathway inhibition in castration resistant prostate cancer which remain sensitive to the inhibitor darolutamide. PMID: 28851578
- c.3864T>C AR novel mutation is responsible for complete androgen insensitivity syndrome [case report] PMID: 29206494
- The Spinal and bulbar muscular atrophy is caused by the expansion of a CAG/glutamine tract in the amino-terminus of the androgen receptor PMID: 29478604
- Polysomic AR genes show low methylation levels and high AR protein expression on immunohistochemistry PMID: 29802469
- Oral administration of RAD140 substantially inhibited the growth of AR/ER(+) breast cancer patient-derived xenografts (PDX). Activation of AR and suppression of ER pathway, including the ESR1 gene, were seen with RAD140 treatment. PMID: 28974548
- The aims of this study was to evaluate if extreme CAG and GGN repeat polymorphisms of the androgen receptors influence body fat mass, its regional distribution, resting metabolic rate, maximal fat oxidation capacity and serum leptin, free testosterone and osteocalcin in healthy adult men PMID: 29130706
- The CRISPR/Cas9 system was able to edit the expression of AR and restrain the growth of androgen-dependent prostate cancer cells in vitro, suggesting the potential of the CRISPR/Cas9 system in future cancer therapy. PMID: 29257308
- A new mechanism for complete androgen insensitivity syndrome (CAIS). A deep intronic pseudoexon-activating mutation in the intron between exons 6 and 7 of AR, detected in two siblings with CAIS, leads to aberrant splicing of the AR mRNA and insufficient AR protein production. PMID: 27609317
- In the current work, we have confirmed that the lead androgen receptor DBD inhibitor indeed directly interacts with the androgen receptor DBD and tested that substance across multiple clinically relevant castration-resistant prostate cancer cell lines PMID: 28775145
- Androgen receptor CAG repeat polymorphism is not associated with insulin resistance and type 2 diabetes in Sri Lankan males. PMID: 29202793
- AR gene CAG repeat polymorphisms are associated with the increased risk of mild endometriosis PMID: 28915409
- ARE full sites generate a reliable transcriptional outcome in AR positive cells, despite their low genome-wide abundance. In contrast, the transcriptional influence of ARE half sites can be modulated by cooperating factors. PMID: 27623747
- Targeting the Malat1/AR-v7 axis via Malat1-siRNA or ASC-J9 can be developed as a new therapy to better suppress enzalutamide-resistant prostate cancer progression. PMID: 28528814
- High circulating AR-V7 levels predicted resistance to abiraterone and enzalutamide in castration-resistant prostate cancer. PMID: 28818355
- Results identified the N-terminal region of AR-V7 (splice variants) that interacts with the diffuse B-cell lymphoma homology (DH) domain of Vav3 which increases its expression in castration-resistant prostate cancer (CRPC). PMID: 28811363
- The single nucleotide polymorphism G1733A of the androgen receptor gene is significantly associated with recurrent spontaneous abortions in Mexican patients. PMID: 28707146
顯示更多
收起更多
-
相關疾病:Androgen insensitivity syndrome (AIS); Spinal and bulbar muscular atrophy X-linked 1 (SMAX1); Androgen insensitivity, partial (PAIS)
-
亞細胞定位:Nucleus. Cytoplasm.
-
蛋白家族:Nuclear hormone receptor family, NR3 subfamily
-
組織特異性:[Isoform 2]: Mainly expressed in heart and skeletal muscle.; [Isoform 3]: Expressed in basal and stromal cells of the prostate (at protein level).
-
數據庫鏈接:
Most popular with customers
-
-
YWHAB Recombinant Monoclonal Antibody
Applications: ELISA, WB, IHC, IF, FC
Species Reactivity: Human, Mouse, Rat
-
Phospho-YAP1 (S127) Recombinant Monoclonal Antibody
Applications: ELISA, WB, IHC
Species Reactivity: Human
-
-
-
-
-